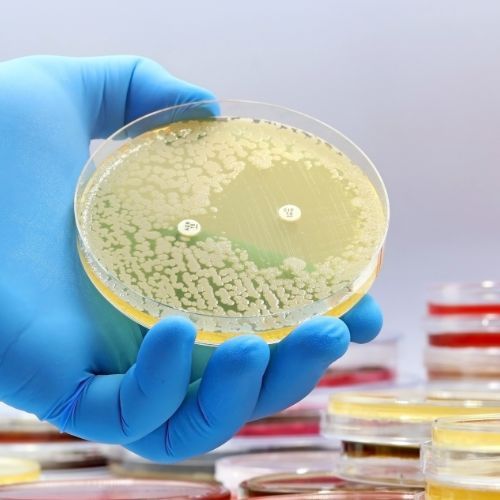

Do 2050 roku będzie zabijać częściej niż nowotwory. Winni są też lekarze

Jeśli bakterie nadal będą uczyć się obrony przed lekami tak szybko jak teraz, za ćwierć wieku nawet drobna infekcja może okazać się śmiertelna. WHO przestrzega, że oporność na antybiotyki może odbierać życie częściej niż nowotwory, a część winy leży po stronie nas wszystkich – od pacjentów po lekarzy.
- Do 2050 r. infekcje oporne na leczenie mogą pochłaniać 10 mln istnień rocznie
- Prognozowana liczba zgonów z powodu raka w tym samym czasie to 8–9 mln osób
- Nadużywanie antybiotyków w medycynie i hodowli zwierząt przyspiesza rozwój „superbakterii”
Niewidzialna pandemia już się zaczęła
Antybiotykooporność to zdolność bakterii do przetrwania kuracji, która kiedyś je zabijała. Światowa Organizacja Zdrowia od lat umieszcza ją wśród największych zagrożeń zdrowia publicznego. Skąd problem?
Po pierwsze, antybiotyki często przepisywane są pacjentom zbyt pochopnie, na przykład przy infekcjach wirusowych, gdzie nie przynoszą żadnego pożytku.
Po drugie, miliardy dawek leków są zużywane w hodowli zwierząt, by przyspieszyć ich wzrost i zapobiec chorobom w zatłoczonych fermach. W tak sprzyjającym środowisku bakterie uczą się, jak omijać kolejne substancje czynne.
10 mln zgonów rocznie w 2050 roku
Ekonomista Jim O’Neill w słynnym raporcie Review on Antimicrobial Resistance oszacował, że brak zdecydowanych działań doprowadzi do 10 mln zgonów rocznie w 2050 r., a globalna gospodarka straci 100 bln USD. Światowa Organizacja Zdrowia i czasopismo The Lancet potwierdzają, że trend jest rosnący. Już dziś infekcje oporne na leczenie odpowiadają za przynajmniej 1,27 mln zgonów rocznie.
Co sprawia, że walka z antybiotykoopornością staje się wyścigiem z czasem?
Tempo narastania problemu – w niektórych regionach świata ponad 60% szczepów bakterii szpitalnych jest niewrażliwych na co najmniej jeden kluczowy lek.
Brak nowych terapii – większość dużych firm farmaceutycznych wycofała się z badań nad antybiotykami; projekty pozostają w rękach małych biotechnologii z ograniczonym budżetem.
Niepotrzebne recepty – Europejskie Centrum ds. Zapobiegania i Kontroli Chorób szacuje, że nawet 30% antybiotyków ordynowanych w podstawowej opiece zdrowotnej nie jest potrzebnych.
Wyższe koszty leczenia – pacjenci z infekcją oporną na leczenie spędzają w szpitalu średnio osiem dni dłużej, a ceny terapii rosną o 20–30%.
Jak spowolnić katastrofę – rola pacjenta i lekarza
Dobra wiadomość jest taka, że każdy z nas może dorzucić cegiełkę do rozwiązania tego problemu. Przede wszystkim warto pytać lekarza, czy antybiotyk naprawdę jest konieczny, i prosić o szybkie testy (na przykład oznaczenie białka CRP z krwi), które pomagają odróżnić infekcję bakteryjną od wirusowej. Jeśli już otrzymasz receptę, bierz lek dokładnie tak długo, jak zalecono – przerwanie kuracji wcześniej zostawia w organizmie najbardziej oporne bakterie.
Błędy zdarzają się też w gabinetach. Kampanie takie jak brytyjskie „Smarter Prescribing” czy polskie „Antybiotykoterapia pod lupą” przypominają lekarzom o korzystaniu z lokalnych danych mikrobiologicznych i konsultowaniu trudnych przypadków ze specjalistami chorób zakaźnych. Równocześnie system powinien wspierać rozwój nowych leków i szczepionek oraz ograniczyć prewencyjne podawanie antybiotyków zwierzętom hodowlanym.
Materiał ma charakter informacyjny i nie zastępuje porady medycznej.
Źródła:
- Tackling Drug-Resistant Infections Globally, raport J. O’Neilla, 2016.
- Murray C. J. L. i in., „Global burden of bacterial antimicrobial resistance in 2019”, The Lancet, 2022.
- Światowa Organizacja Zdrowia – system GLASS i raport Global Health Estimates, 2024.
- Europejskie Centrum ds. Zapobiegania i Kontroli Chorób – dane o zużyciu antybiotyków, 2024.








































